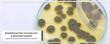

Biotherapeutics Cell Line Development Market Qualitative Insights on Application & Outlook by Size, Share, Future Growth

Pharmaceutical and biotechnology companies, research laboratories, and clinical research are the major consumers of biotherapeutic cell line development market PORTLAND, OREGON, US, February 3, 2022 /EINPresswire.com/ -- According to the " …